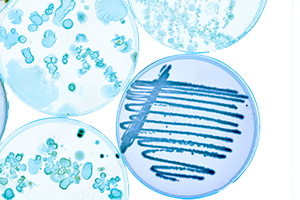
Image

深耕微生物底盘细胞改造与微生物药物工艺开发
合规高效 高产稳定

公司产品
Our Products
酶制剂
Enzymes
生物原料药制造用酶:重组肠激酶,重组胰蛋白酶,重组赖氨酰内切酶等;
化学原料药制造用酶:重组羰基还原酶,重组棘白菌素酰化酶,重组α-氨基酯水解酶等;
医美原料制造用酶:重组酪氨酸酶,重组脯氨酸羟化酶等。

发酵原料药与中间体
抗感染类:棘白菌素B,莫匹罗星,卡那霉素,新霉素,去甲金霉素等;
免疫抑制类:西罗莫司,他克莫司,伏环孢菌素等;
其他:R-α-硫辛酸

生物原料药与中间体
GLP-1类:利拉鲁肽中间体,司美格鲁肽中间体,替尔泊肽中间体等;
胰岛素类:德谷胰岛素前体,依柯胰岛素中间体,门冬胰岛素等;
骨质疏松类:特立帕肽等。

医美原料
Cosmetic Raw Materials
修复类:重组贻贝粘蛋白系列,重组蓝铜肽等;
抗氧化类:麦角硫因等。
噬菌体
Phages
抗皮炎类:金黄色葡萄球菌噬菌体,大肠杆菌噬菌体等;
抗痤疮类:痤疮丙酸杆菌噬菌体。

产品定制
Custom Materials
承接噬菌体,特种酶,重组多肽和重组蛋白生物合成定制。

特色服务
Our Applications
为您提供从菌种构建、选育、建库,到发酵工艺、下游工艺开发与中试现场指导的一站式服务。
微生物菌种选育/Industrial Strain Development
传统法菌种选育,合成生物学底盘细胞改造,重组多肽与蛋白工程菌构建等。
发酵类原料药生产工艺开发/Microbial Drug Product Development
发酵类抗生素,半合成类抗生素,微生物药物,GLP-1多肽药物,PTH多肽药物,重组类胰岛素等。
酶工程与生物转化/Enzyme Engineering & Biocatalysis Services
新酶筛选,定向进化,理性设计,半理性改造,定点修饰,酶分子动力学模拟,全细胞催化,固定化改造等。
选择英普博集
Why Choose Enzpro
公司核心研发团队由行业精英技术专家组成,成员平均拥有超过18年的微生物药物研发经历和中试工艺放大经验。公司研发人员中博士和硕士学历超过60%,拥有国内授权专利19项,国际专利1项。目前公司已开发多项交叉性工程技术,并在多个复杂项目难点攻关上取得成功。
专业全面/Professional
提供微生物药物原料菌种、上游和下游全流程技术开发与优化服务。
品质优异/High-Quality
以客户需求为中心,以项目痛点为目标,为客户提供满意、合规的项目交付与中试现场指导。
经济实惠/Cost-Efficient
通过不断的技术革新与集约化管理,为客户实现经济节约的项目开发支出。
让酶成就生活之美
A better life with enzyme
